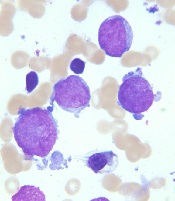

Image courtesy of St. Jude
Children’s Research Hospital
and Tina Motroni
Research has revealed genetic alterations that may prove useful for predicting treatment outcomes in pediatric patients with acute megakaryoblastic leukemia (AMKL) who do not have Down syndrome.
The study suggests that 3
genetic alterations can be used to identify high-risk patients who may benefit
from allogeneic stem cell transplant, and 1 alteration may identify
low-risk patients who require less chemotherapy than their peers.
Researchers said these findings, published in Nature Genetics, support revised diagnostic screening and treatment recommendations for pediatric AMKL.
“Because long-term survival for pediatric AMKL patients without Down syndrome is poor, just 14% to 34%, the standard recommendation by many pediatric oncologists has been to treat all patients with allogeneic stem cell transplantation during their first remission,” said study author Tanja Gruber, MD, PhD, of St. Jude Children’s Research Hospital in Memphis, Tennessee.
“In this study, we identified several genetic alterations that are important predictors of treatment success. All newly identified pediatric AMKL patients without Down syndrome should be screened for these prognostic indicators at diagnosis. The results will help identify which patients need allogeneic stem cell transplants during their first remission and which do not.”
This study involved next-generation sequencing of the whole exome or RNA of 99 AMKL patients without Down syndrome (75 pediatric and 24 adult patients). Along with the sequencing data, researchers analyzed patients’ gene expression and long-term survival.
Results
The results showed that non-Down syndrome pediatric AMKL can be divided into 7 subgroups based on the underlying genetic alteration, pattern of gene expression, and treatment outcome.
The subgroups include the newly identified HOX subgroup. About 15% of the pediatric patients in this study were in the HOX subgroup, which is characterized by several different HOX fusion genes.
The researchers also identified cooperating mutations that help fuel AMKL in different subgroups. The cooperating mutations include changes in the RB1 gene and recurring mutations in the RAS and JAK pathways.
In addition, the study showed that 3 genetic alterations—CBFA2T3-GLIS2, KMT2A rearrangements, and NUP98-KDM5A—are associated with reduced survival in pediatric AMKL subtypes.
The researchers said patients with these alterations may benefit from allogeneic stem cell transplants, so non-Down syndrome pediatric AMKL patients should be screened for these alterations at diagnosis.
The team also recommended testing AMKL patients for mutations in the GATA1 gene. GATA1 mutations are a hallmark of AMKL in children with Down syndrome, who almost always survive the leukemia. In this study, AMKL patients with GATA1 mutations and no fusion gene had the same favorable outcomes.
“The results raise the possibility that pediatric AMKL patients without Down syndrome who have mutations in GATA1 may benefit from the same reduced chemotherapy used to treat the leukemia in patients with Down syndrome,” Dr Gruber said.
These revised diagnostic screening and treatment recommendations are being implemented at St. Jude.
This study also showed that adults with AMKL lacked recurrent fusion genes. The most common mutations found in the adult patients were in TP53 (21%), cohesin genes (17%), splicing factor genes (17%), ASXL genes (17%), and DNMT3A (13%). About 4% had GATA1 mutations.


